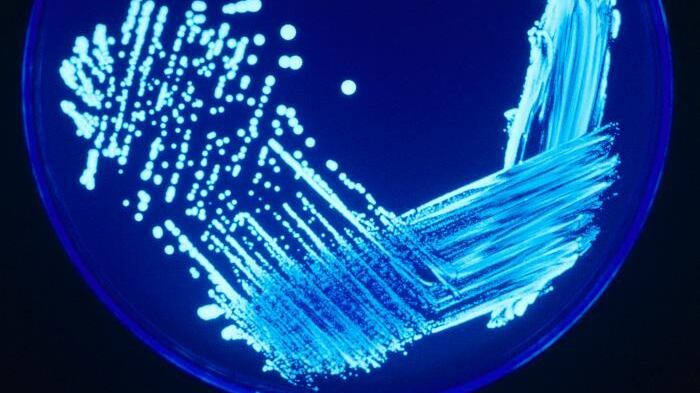

MADRID, 4 (EUROPA PRESS)
Los 18 casos mortales presentaban comorbilidades y tenían edades comprendidas entre los 53 y los 98 años (9 hombres y 9 mujeres). A fecha de 24 de agosto de 2023, se han recogido 56 muestras de agua en instalaciones de edificios de Rzeszów, Rzeszów poviat, Ropczyce y Sedziszów poviat.
En Rzeszów se han cerrado fuentes e instalaciones de agua. De hecho, Rzeszów Empresa Municipal de Aguas y Alcantarillado planificó la desinfección de la red de abastecimiento de agua de la ciudad de Rzeszów y ciudades adyacentes el 27 de agosto de 2023.
Además, se ordenó a las unidades sanitarias y a los centros de cuidados de larga duración que realizaran inspecciones adicionales de sus sistemas de agua.
Por otro lado, el 25 de agosto de 2023, el Ministerio de Sanidad y la Inspección Sanitaria de Polonia informaron de que se había llevado a cabo una investigación epidemiológica, que incluía entrevistas con pacientes o familiares.
ANTECEDENTES
Entre 2016 y 2021, Polonia notificó anualmente entre 20 y 70 casos de legionelosis al Sistema Europeo de Vigilancia de la Legionelosis (TESSy). En 2022, esta cifra aumentó a 111 casos notificados.
Tal y como recuerda el ECDC, los brotes de legionelosis son causados por la inhalación de gotitas de agua en aerosol portadoras de la bacteria 'Legionella'.
Aunque todavía no se ha informado de una fuente identificada para este brote, se han aplicado medidas de control preventivas para reducir el riesgo de infección por posibles fuentes ambientales. El riesgo de infección se limita a una zona geográfica localizada en torno a la fuente del brote. A fecha de 30 de agosto de 2023, no se ha notificado ningún caso asociado a viajes al ECDC para alojamientos en Rzeszów.